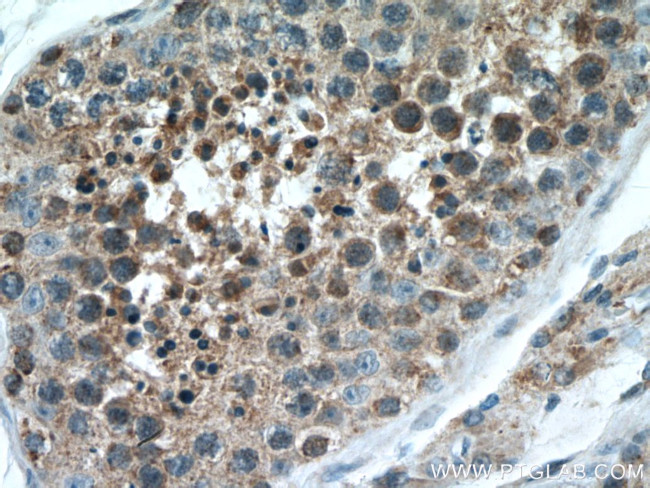
IZUMO1 Antibody in Immunohistochemistry (Paraffin) (IHC (P))

Search
Proteintech
IZUMO1 Polyclonal Antibody
{{$productOrderCtrl.translations['antibody.pdp.commerceCard.promotion.promotions']}}
{{$productOrderCtrl.translations['antibody.pdp.commerceCard.promotion.viewpromo']}}
{{$productOrderCtrl.translations['antibody.pdp.commerceCard.promotion.promocode']}}: {{promo.promoCode}} {{promo.promoTitle}} {{promo.promoDescription}}. {{$productOrderCtrl.translations['antibody.pdp.commerceCard.promotion.learnmore']}}
产品信息
13296-1-AP
宿主/亚型
分类
类型
抗原
偶联物
形式
浓度
规格
保存条件
运输条件
产品详细信息
Immunogen sequence: LALKSLEKD YLPGHLDAKH HKAMMERVEN AVKDFQELSL NEDAYMGVVD EATLQKGSWS LLKDLKRITD SDVKGDLFVK ELFWMLHLQK ETFATYVARF QKEAYCPNKC GVMLQTLIWC KNCKKEVHAC RKSYDCGERN VEVPQMEDMI LDCELNWHQA SEGLTDYSFY RVWGNNTETL VSKGKEATLT KPMVGPEDAG SYRCELGSVN SSPATIINFH VTVLPKMIKE EKPSPNIVTP GEATTESSIS LQPLQPEKML ASRLL (31-294 aa encoded by B C034769)
靶标信息
The sperm-specific protein Izumo, named for a Japanese shrine dedicated to marriage, is essential for sperm-egg plasma membrane binding and fusion.The sperm-specific protein Izumo, named for a Japanese shrine dedicated to marriage, is essential for sperm-egg plasma membrane binding and fusion.
仅用于科研。不用于诊断过程。未经明确授权不得转售。